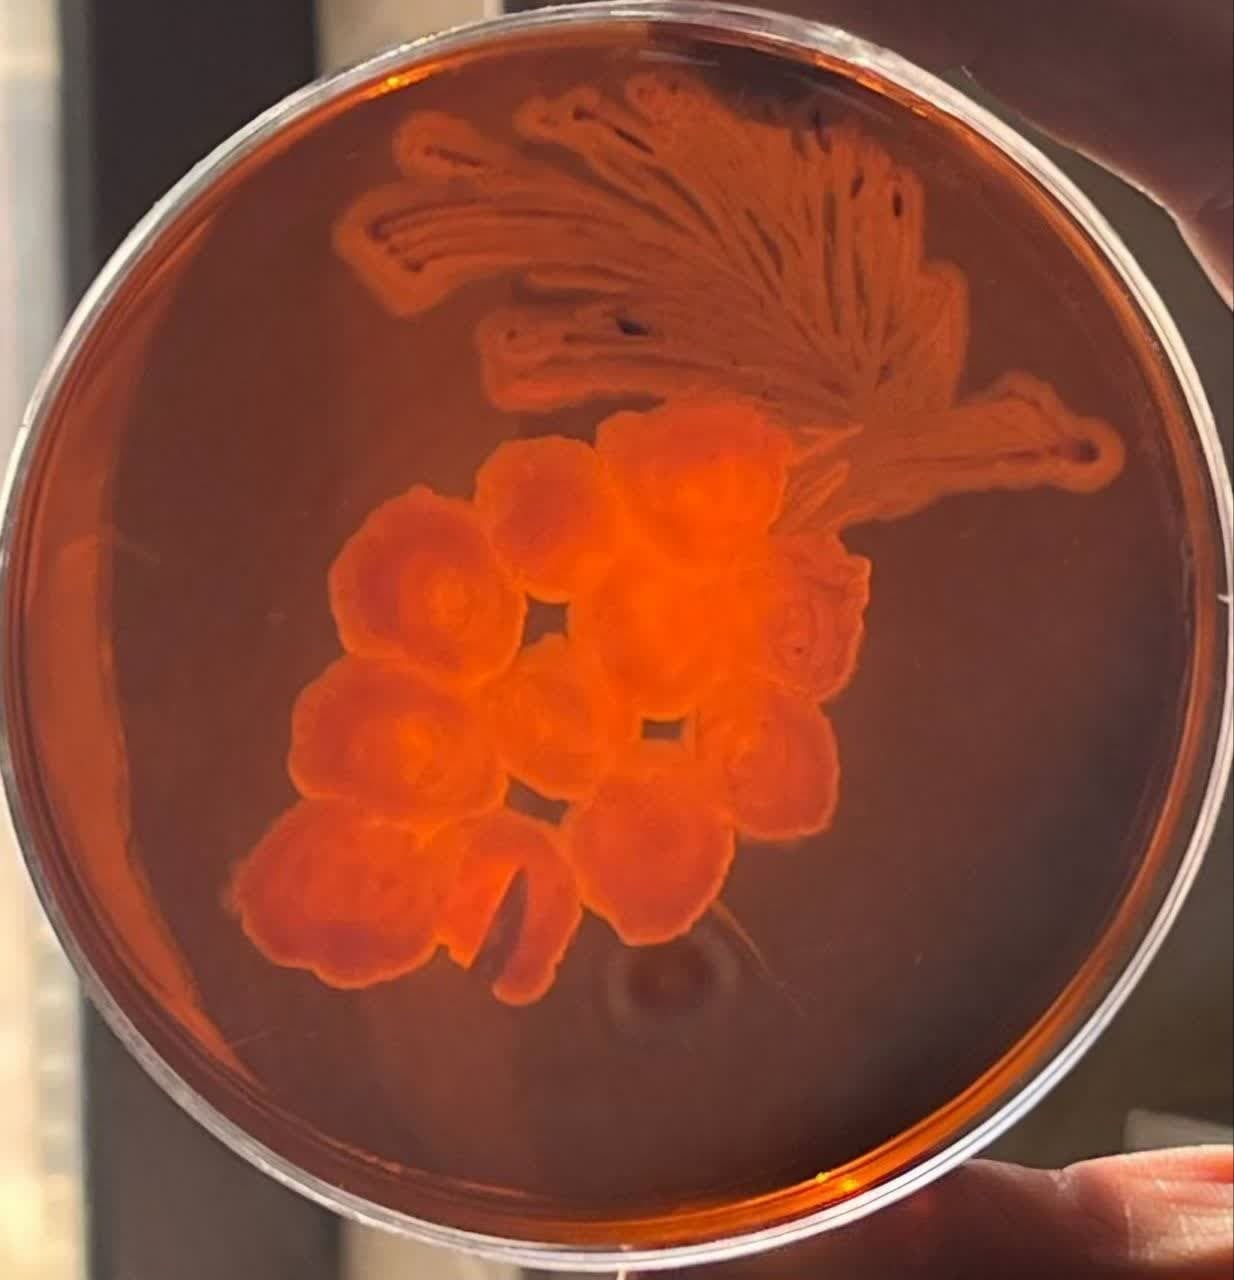
خلق آثار هنری با استفاده از باکتری‌ها

خلق آثار هنری با باکتریها
الهام نوروزی عضو هیئتعلمی گروه میکروبیولوژی دانشگاه آزاد اسلامی واحد شاهرود در گفتوگو با خبرنگار آنا با اشاره به برگزاری نمایشگاه نقاشی آگار با باکتریها در این واحد دانشگاهی اظهار کرد: این نمایشگاه هنری منحصربهفرد بوده که در آن باکتریها بهعنوان مواد اولیه برای خلق آثار هنری جذاب استفاده میشوند.
وی افزود: باکتریها از جالبترین موجودات زنده هستند که با چشم غیرمسلح دیده نمیشوند؛ اما همیشه و همهجا حضور دارند. در حال خوردن، خوابیدن، کار کردن و همه شرایط در کنار ما هستند. هر باکتری میتواند با توجه به رنگ، شکل، شرایط محیطی و ویژگیهای خاص خود تأثیر متفاوتی بر محیط کشت بگذارد و اشکال جذاب و غیرمنتظرهای را خلق کند.

عضو هیئتعلمی گروه میکروبیولوژی دانشگاه آزاد اسلامی واحد شاهرود ادامه داد: در نمایشگاه نقاشی آگار با باکتریها از محیطهای کشت آگار برای پرورش باکتریها در طرحهای مختلف بهره گرفته میشود و هر باکتری میتواند با توجه به نوع آن رنگ شکل و ویژگیهای خاص خود تأثیر متفاوتی بر محیط کشت بگذارد و نقاشیهای جالب و اغلب غیرمنتظرهای را خلق کند.
نوروزی عنوان کرد: این نمایشگاه، نهتنها به نمایش زیباشناسی بینظیر میکربها میپردازد؛ بلکه تلاشی است برای نشان دادن تفاوتهای بیولوژیکی و تعاملات پیچیده موجودات میکروسکوپی که بهراحتی از چشم انسان پنهان میمانند و در این گالری شاهد این خواهیم بود که چگونه موجودات کوچک میتوانند تصاویری منحصربهفرد و خارقالعاده خلق کنند که بهنوعی بازتابدهنده پیچیدگیهای زیستی و هنری طبیعت باشند.
وی نمایشگاه نقاشی آگار با باکتریها بیان کرد: هدف از برگزاری این رویداد، آشنایی بیشتر دانشجویان با علم میکروبیولوژی و ایجاد علاقه و انگیزه و ارتقای علمی آنهاست. اطمینان داریم رویداد گالری باکتریها میتواند نقش بسیار مؤثری در راستای افزایش دانش و توانمندیهای دانشجویان و علاقهمندان رشته میکروبیولوژی داشته باشد و با توسعه آن میتوانیم شاهد دستاوردهای چشمگیری در این رشته باشیم.

عضو هیئتعلمی گروه میکروبیولوژی دانشگاه آزاد اسلامی واحد شاهرود از دانشجویان همکارش به نامهای محراب تورانی(دانشجوی میکروبیولوژی، سرپرست گروه و عضو باشگاه پژوهشگران جوان)، عرفان بانی(دانشجوی میکروبیولوژی و طراح، عضو باشگاه پژوهشگران جوان)، محمد مهرآمیز و مریم عامری(دانشآموختگان دانشگاه آزاد شاهرود، کارشناسان ارشد گروه و امیرمهدی اسکندری(دانشجوی میکروبیولوژی) که در این پروژه یاریگر بودند، قدردانی کرد.
انتهای پیام/